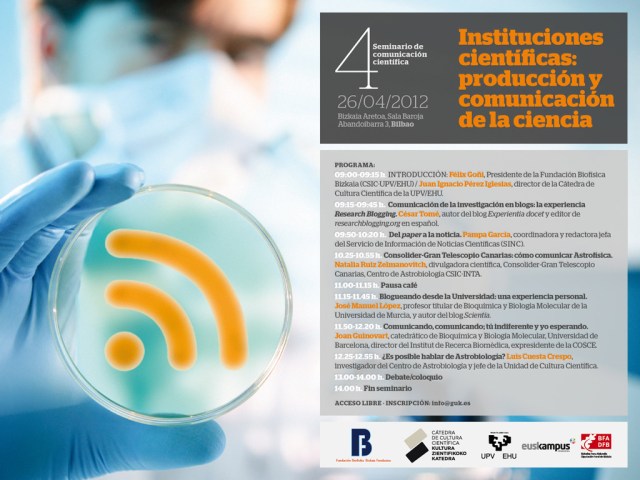
programa3

Todos los aficionados al deporte rey, una de las grandes aficiones de un servidor como muchas veces he reconocido en este blog, saben que el escenario preferido por la gran mayoría de los futbolistas de este país para jugar los grandes partidos es el estadio bilbaíno de “San Mamés”, la Catedral del fútbol español.
Pues bien, si hiciesen una encuesta entre los amantes de la divulgación científica, la gran mayoría de ellos también elegirían Bilbao como la ciudad donde se cuida la divulgación como en muy pocos sitios… y sin lugar a duda la Cátedra de Cultura Científica de la UPV/EHU dirigida por Juan Ignacio Pérez Iglesias tiene mucha parte de culpa.
Organización de jornadas, ciclos de conferencias, mesas redondas y eventos similares son algunas de las muchas actividades que la Cátedra de Cultura Científica organiza anualmente y que la han hecho un referente a nivel nacional en el mundo de la divulgación de la Ciencia.
Un claro ejemplo de lo dicho es el “4º Seminario de comunicación científica” que se celebrará el día 26 de abril en el incomparable marco del Bizkaia Aretoa y que dicha Cátedra organiza conjuntamente con la Fundación Biofísica Bizkaia (CSIC-UPV/EHU) presidida por Félix Goñi.
En esta cuarta edición del seminario de comunicación científica, que llevará por título “Instituciones científicas: producción y comunicación de la ciencia” y cuyo programa adjuntamos en este post, se abordará un tema de rabiosa actualidad en el mundo de la divulgación, la problemática existente a la hora de comunicar a la sociedad los resultados científicos que se obtienen en diferentes centros de investigación (Universidades y OPIs).
Los lectores asiduos de este blog saben que en numerosas ocasiones hemos incidido en que, a pesar de que a veces se escucha lo contrario, la sociedad está ávida porque se le ofrezca información científica de una forma amena y comprensible. Con este propósito, en esta jornada distintos blogueros, profesores universitarios, investigadores del CSIC o la coordinadora del servicio de información de noticias científicas (SINC) nos explicarán diferentes formas de dar a conocer a la población las ventajas y utilidades de las investigaciones que se llevan a cabo en nuestros centros de investigación, intentando acercar la sociedad al científico.
Tengo que reconocer que para mí es un verdadero honor haber sido invitado a impartir una charla en el “4º Seminario de comunicación científica” y que llevará por título “Blogueando desde la Universidad: una experiencia personal”. Durante treinta minutos intentaré dar, al más puro estilo Scientia, mi visión acerca de las ventajas e inconvenientes de divulgar la ciencia a través de un blog desde una Universidad, el papel del docente universitario como divulgador de la ciencia en las aulas y fuera de ellas y, sobre todo, cómo desde Scientia intentamos divulgar a la sociedad las investigaciones que hacemos en nuestros propios laboratorios de la Universidad de Murcia.
Sinceramente les recomiendo a todos ustedes que si pueden se acerquen al Bizkaia Aretoa de la UPV/EHU (Avda. Abandoibarra, nº 3, Bilbao) el próximo 26 de abril. La entrada será libre y pueden inscribirse en info@guk.es. No se arrepentirán.
PROGRAMA
“Instituciones científicas: producción y comunicación de la ciencia”
9:00/9:15: Introducción: Félix Goñi, Presidente de la Fundación Biofísica Bizkaia (CSIC-UPV/EHU) y Juan Ignacio Pérez, Director de la Cátedra de Cultura Científica (UPV/EHU)
9:15/9:45: César Tomé, autor del Blog ‘Experientia docet’ y editor de ResearchBlogging.org en español: “Comunicación de la investigación en blogs: la experiencia Research Blogging”
9:50/10:20: Pampa García, coordinadora y redactora jefa del Servicio de Información de Noticias Científicas (SINC): “Del paper a la noticia”
10:25/10:55: Natalia Ruiz Zelmanovitch, divulgadora científica, Consolider-Gran Telescopio Canarias, Centro de Astrobiología CSIC-INTA: “Consolider-Gran Telescopio Canarias: Cómo comunicar astrofísica”
11:00/11:15: PAUSA CAFÉ
11:15/11:45: José Manuel López, Profesor Titular de Bioquímica y Biología Molecular de la Universidad de Murcia, y autor del Blog ‘Scientia’: “Blogueando desde la Universidad: Una experiencia personal”.
11:50/12:20: Joan Guinovart, Catedrático de Bioquímica y Biología Molecular, Univ. de Barcelona, Director del “Institut de Recerca Biomèdica” y expresidente de la COSCE: “Comunicando, comunicando; tú indiferente y yo esperando”
12:25/12:55 horas: Luis Cuesta Crespo, investigador del Centro de Astrobiología y Jefe de la Unidad de Cultura Científica: “¿Es posible hablar de Astrobiología?”
13:00/14:00 horas: Debate-coloquio
14:00 horas: FIN SEMINARIO
Nos vemos en Bilbao,
Jose

Reblogged this on elaiso.
habeis visto esto? pues deberíais…
http://www.abc.es/20120330/medios-redes/abci-multinacional-cosmetica-201203301000.html
Voy a tener que tirarle de las orejas a Iñako. Ni un puñetero periodista en el plantel… En fin, así saldrá 😛
Hay una periodista; una profesional como la copa de un pino; y los demás son verdaderos artistas. 😉
Hay una periodista (Pampa García Molina) que es una profesional como la copa de un pino. Y los demás son unos artistas. Pues eso, así saldrá, y espero verte por allí para que tú lo veas.
Pingback: Amazings Zientziateka…Amazings Revista…Amazings Divulga | SCIENTIA
Pingback: La Universidad y los blogs científicos “personales”… ese bonito “pasatiempo” | SCIENTIA
Interesante, me apasiona mucho el tema de los blogs. Yo los uso para el desarrollo de la temática relacionada con la tecnología educativa. http://normantrujillo.wordpress.com/
Me interesa mucho poder tener acceso al material utilizado en el seminario.
Saludes desde Nicaragua.
Pingback: Amazings Zientziateka…Amazings Revista…Amazings Divulga | SapienScientia
Pingback: La Universidad y los blogs científicos “personales”… ese bonito “pasatiempo” | SapienScientia
Pingback: “Blogueando desde la Universidad: una experiencia personal”… y mucho más | SCIENTIA
Pingback: Scientia: 2 años, 200 posts… y mucho más | SCIENTIA